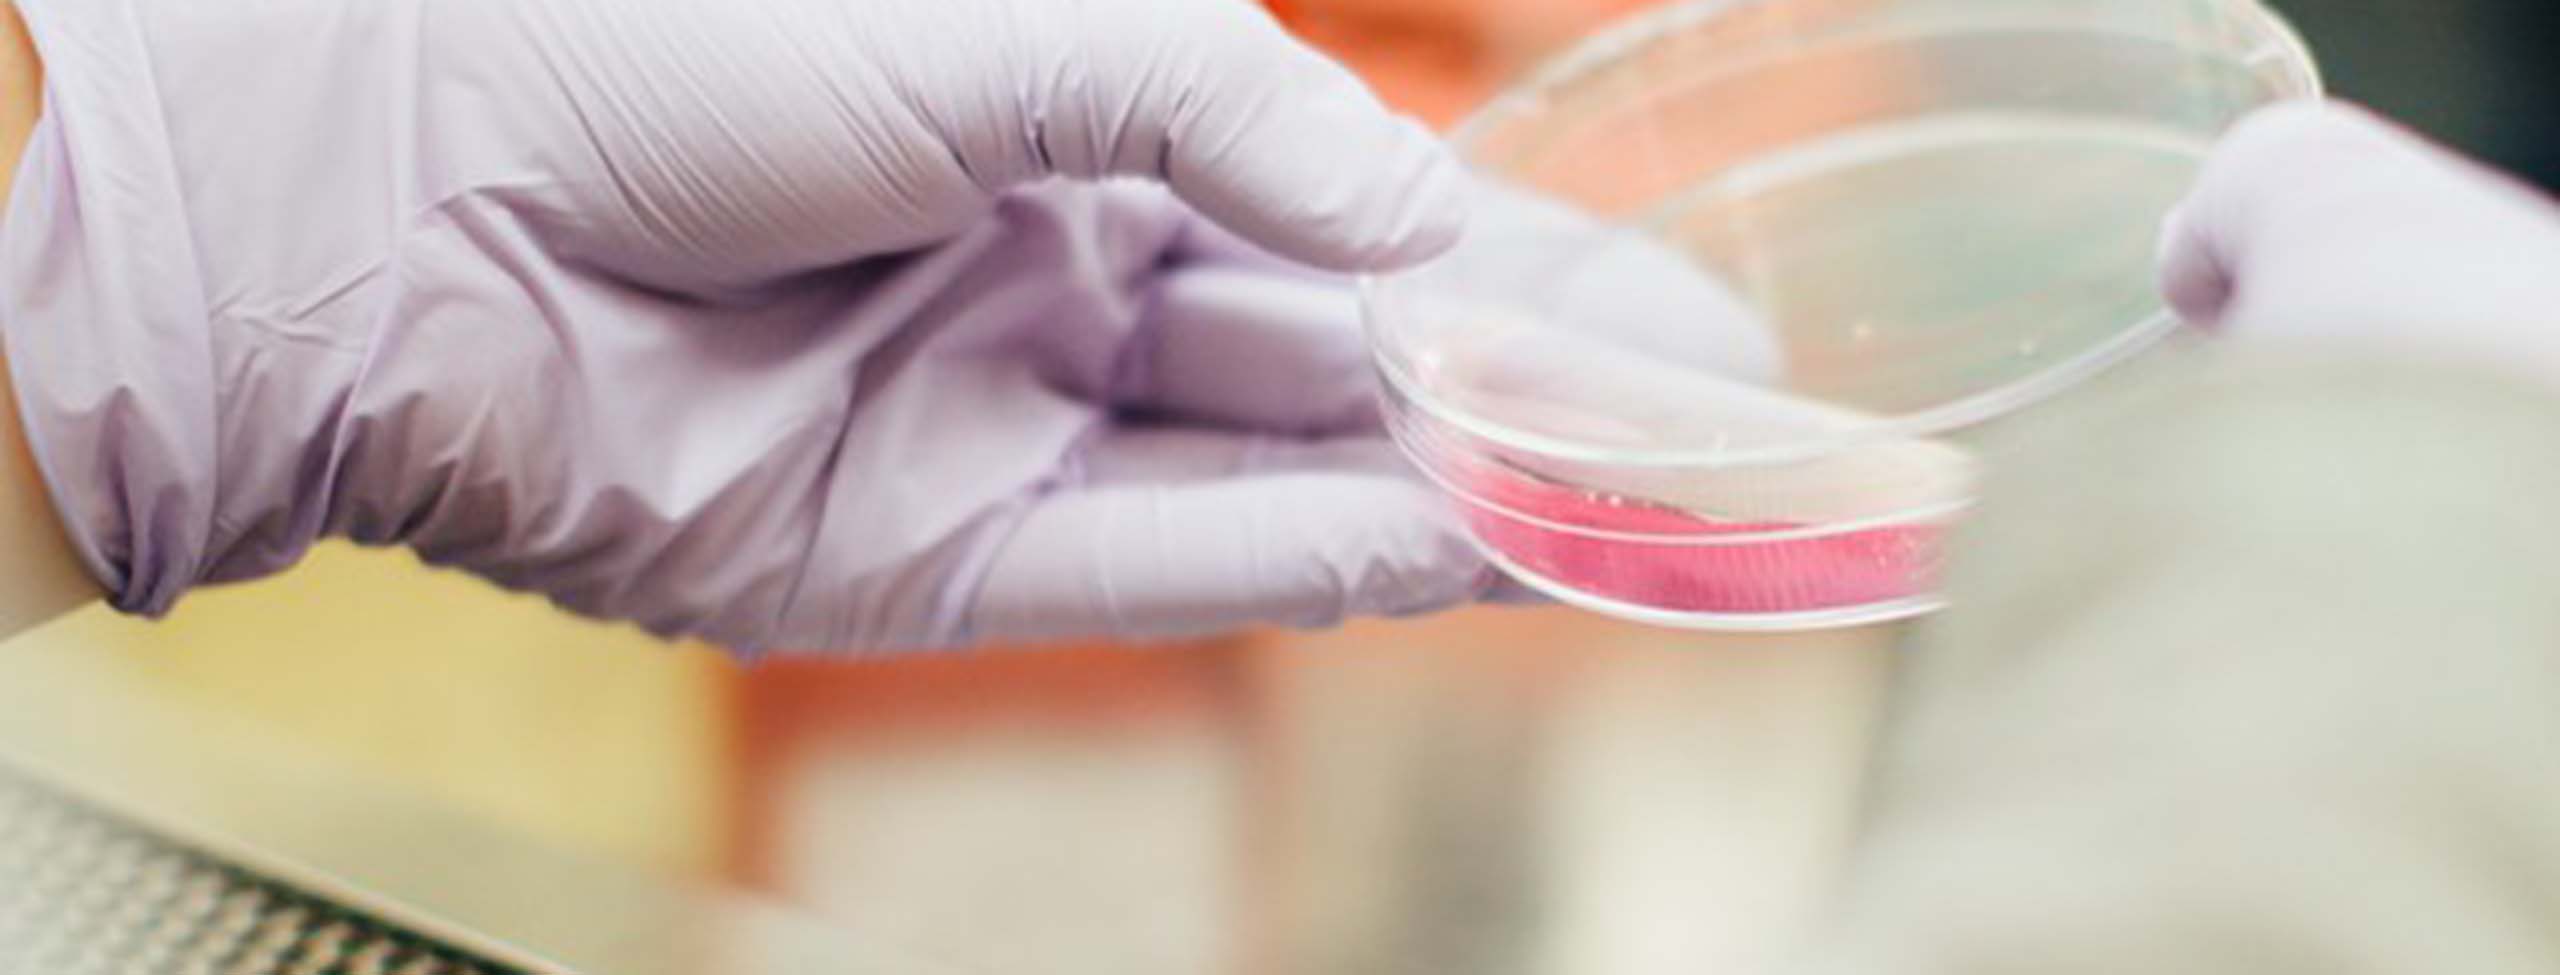

.jpg?impolicy=m&im=Resize,width=3840)
10 June 2024 • 8 minute read
FDA issues Platform Technology Designation Program for Drug Development draft guidance
On May 29, 2024, FDA released its draft Platform Technology Designation Program for Drug Development: Guidance for Industry.
The long-awaited draft guidance describes the process for requesting and receiving a platform technology designation, which would provide an expediated pathway for the development of drugs or biologics that utilize a platform technology to standardize the development, manufacture, or processing of the finished product.
The draft guidance represents a potentially significant shift in the regulatory and commercial strategies for novel drug and biologics products that may have lasting impacts on product development.
Background
The Consolidated Appropriations Act, 2023 (Public Law 117-328) established section 506K of the Federal Food, Drug, and Cosmetic Act (FDCA), which directs FDA to create a program for the establishment of platform technologies and platform technology designations. A platform technology is a well-understood and reproducible technology, such as a nucleic acid sequence, molecular structure, mechanism of action, delivery method, vector, or any combination thereof.
Platform technologies:
- Can be incorporated in or used by a drug or biological product and are essential to the structure or function of the drug or biological product
- Can be adapted for, incorporated into, or used by one or more drug or biological products sharing common structural elements, or
- Facilitate the manufacture or development of drug or biological products through a standardized manufacturing production or manufacturing process or processes.
Platform technologies offer the potential to revolutionize drug development by creating new and more effective ways to target specific organs or tissues while minimizing effects on surrounding tissue or organ systems or by facilitating more effective delivery of the therapy in the body. For example, adeno-associated viruses (AAVs), adenoviruses, and lentiviruses are commonly used vectors in gene and cell therapy that have been shown to be effective platform technologies for packaging and delivering gene therapies to target tissues within the body. A platform technologies designation can also optimize traditional manufacturing by streamlining FDA’s traditional review of chemistry manufacturing and controls (CMC) and other aspects of pre-market safety review.
The draft guidance responds to the growing need to adapt new approaches to premarket review for platform technologies, which may not fit squarely within FDA’s traditional drug and biologic approval processes. In a traditional drug or biologic approval process, a sponsor whose technology incorporates or relies upon a platform technology must obtain approval for (i) the platform technology itself (ie, the mechanism through which the drug or biologic will be delivered) as well as (ii) the actual drug or biologic of interest, demonstrating that each component is safe and effective each time. This adds time and additional layers of review for each use of the platform technology.
By allowing a sponsor to request that FDA designate a process, software, or other technology as a platform technology, that same sponsor could streamline the drug or biologic approval process for future products that rely on the same underlying platform technology because FDA would not have to re-review and approve the platform technology each time. Sponsors with a platform technology designation could also grant other companies a right of reference to the platform technology, enabling them to use the same platform technology if they have the potential to be incorporated in or used by more than one drug or biologic without adverse effects on quality, manufacturing, or safety.
FDA has adopted similar approaches for qualifying tools that can be utilized to develop multiple products for other research and development activities, such as FDA’s Advanced Manufacturing Technologies Designation Program (AMT), CDER Biomarker Qualification Program (BQP), Drug Development Tool (DDT), and Medical Device Development Tool (MDDT) programs. The regulatory concept, while different in its application to platform technologies, has regulatory foundations in other FDA regulatory and product areas.
Eligibility factors for receiving platform technology designation
The eligibility factors for receiving a platform technology designation are set forth in section 506K(b) of the FDCA. FDA notes that a technology may meet the definition of a platform technology in section 506K, but it may fail to satisfy the criteria set forth in section 506K(b). FDA provides further detail on how to apply these factors in its draft guidance.
The eligibility factors are as follows:
- The platform technology is incorporated within or used by an FDA-approved drug or biologic product.
- Preliminary evidence submitted by the sponsor of the FDA-approved drug or biologic (or a sponsor granted a right of reference by the original sponsor) demonstrates that the platform technology has the potential to be incorporated in or used by more than one drug without an adverse effect on quality, manufacturing, or safety.
For FDA’s purposes, “preliminary evidence” means information from completed tests or studies comparing the use of the platform technology in the FDA-approved drug or biologic versus the proposed use of it in the investigational drug or biologic. Such evidence may include demonstrating that the drugs are structurally similar, that there are minimal differences in product formulation (qualitatively and quantitatively), or that there are nearly identical manufacturing processes.
FDA also indicates that there should be “minimal differences” between the approved drug or biologic and the investigational drug or biologic that proposes to use the same platform technology.
Sponsors should include summary data, with adequate jurisdiction, to show that certain product-specific tests, analyses, or studies can be leveraged. Sponsors should also include assessments of any of their products that use the platform technology regardless of development or marketing status.
- Data or information submitted indicates that incorporation or use of the platform technology has a reasonable likelihood to bring significant efficiencies to the drug development or manufacturing process as well as to the review process.
“Significant efficiencies” means that a prior test, study, or manufacturing process could be leveraged in a subsequent application to allow the product in the subsequent application to be developed or reviewed in a more streamlined manner.
Sponsors are encouraged to provide detailed justifications for the above – FDA provides information on recommended content of the designation request in Section C of the draft guidance. Sponsors can use traditional meeting pathways to discuss a potential platform technology designation with FDA. They can also make a separate request for a platform technology designation discussion.
FDA will review and issue a determination within 90 days of receipt, and, if it grants platform technology designation, it may take actions to expedite the development and review of any subsequent new drug application or biologics license application for a product that uses or incorporates the platform technology. Of note, FDA can revoke the designation if the platform technology no longer meets the eligibility factors. FDA will communicate a revocation and its rationale for the revocation in writing.
FDA also provides specific considerations for eligibility for the following specific platform technologies: lipid nanoparticle platforms for mRNA vaccine or gene therapy products; monoclonal antibody platforms; platforms using a chemically defined targeting moiety in conjunction with a well-characterized synthetic siRNA; and lipid nanoparticle platforms encapsulating different short, single-stranded or double-stranded oligonucleotides.
FDA clarifies that failure to receive platform technology designation does not preclude a sponsor from otherwise using prior knowledge (eg, through a letter of authorization to an approved drug or biologic or traditional bridging studies).
Additional potential benefits of platform technology designation
- Opportunities for agency engagement: Applying for a platform technology designation will allow sponsors an avenue to engage with and receive timely advice from FDA on information the Agency believes to be relevant in establishing, eg, the safety, purity, potency, or quality of a product. Further, where FDA believes a product has significant potential benefit to the public health, it has indicated it may prioritize interactions or additional engagements with a sponsor regarding a designated platform technology.
- Opportunities to leverage data: Future sponsors may be able to leverage data from a prior product that used the designated platform technology as prior knowledge (eg, batch and stability data; certain nonclinical safety data), potentially even replacing the need for product-specific assessments for specific, designated endpoints.
- Opportunities to learn from real-world data or evidence: FDA may be able to leverage prior inspectional findings related to the manufacture of an FDA-approved product that incorporates or uses the designated platform technology.
Stakeholders can comment on the draft guidance at Regulations.gov, Docket FDA-2024-D-1829-0002, through July 29, 2024.